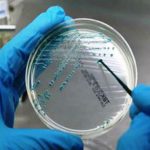
Emergenza polmonite nel Bresciano: è legionella?

“L’evoluzione delle professioni infermieristiche incide in modo determinate nell’evoluzione del complesso delle politiche sanitarie”.
È così che il sindaco di Ravenna Michele de Pascale, in occasione del convegno ‘I nuovi scenari della professione infermieristica’ (organizzato lo scorso sabato dall’Ordine provinciale), ha iniziato la sua arringa.
Un discorso, il suo, che ha toccato diversi temi e che ha voluto stimolare delle riflessioni importanti sui motivi per cui la professione stenta a decollare e, più in generale, sulle politiche per la salute dei cittadini.
Crisi a parte, che negli ultimi decenni si sia sbagliato qualcosa in termini di programmazione (viste le condizioni attuali del nostro Servizio Sanitario Nazionale, non nel suo periodo migliore), è assai palese. E sul tema il primo cittadino romagnolo non le manda di certo a dire: “Oggi dobbiamo fare tre importanti denunce che devono essere all’attenzione di chiunque si occupi di politiche sanitarie e che sono determinanti per la qualità dei servizi nel territorio” ha tuonato.
Per poi elencarne una ad una, partendo dal fumo negli occhi che, spesso e volentieri, la politica italiana prova a gettare negli occhi dei suoi cittadini: “La prima, il sotto-finanziamento del servizio sanitario nazionale. Anche se in passato ci si è vantati di non aver fatto tagli in sanità, il fatto di non aver aumentato le risorse ha significato operare tagli, poiché, evolvendo costantemente le cure, di conseguenza aumentano anche i costi e in parallelo cresce la popolazione anziana. Questo si ripercuote in maniera molto forte sulle possibilità di assumere e formare professionisti.”
Assumere e formare… Verbi importantissimi, questi, in ambito sanitario e soprattutto infermieristico. Perché quando non si assume, i lavoratori vengono spremuti e sfruttati fino all’inverosimile. Fino allo svilimento e alla mortificazione professionale, visto che essendo “responsabili dell’assistenza generale infermieristica”, ai professionisti infermieri viene imposto di fare un po’ di tutto; e ciò con solite scuse come “il paziente è al centro”, “non ci sono gli oss e quindi bisogna fare anche il loro lavoro”, ecc. Sotto ricatto, per giunta, visto che molto spesso il personale ‘spremuto’ e umiliato è precario e senza alcuna tutela.
E poi c’è la questione economica, talmente tanto importante da mettere un po’ tutto il resto in secondo piano. “Secondo tema: si chiede alle professioni infermieristiche di rivestire un ruolo sempre più importante, ma questo non si accompagna a investimenti sulla formazione continua, corsi di specializzazione, possibilità di prosecuzione della propria carriera accademica e anche ad adeguati riconoscimenti economici.
Perché in un momento di medicina difensiva come quello a cui assistiamo, a maggiori responsabilità degli infermieri devono anche essere collegati maggiori profili retributivi” ha continuato De Pascale.
Che ha poi dato una sacrosanta e inevitabile mazzata finale, attaccando indirettamente le menti illustri che hanno programmato l’evoluzione della nostra sanità senza prevedere il disastro in cui ci troviamo oggi:
“Terzo elemento, un grido di allarme: negli ultimi vent’anni sono state sbagliate tutte le politiche di programmazione e formazione delle professioni sanitarie. Già oggi, ma nei prossimi anni ancora di più, ci troveremo in una grave carenza di medici, infermieri e altre figure professionalizzate. È stato un errore enorme in termini di programmazione: se guardiamo il trend dei pensionamenti, una volta finito l’effetto della legge Fornero inseriremo nel mercato del lavoro molti meno professionisti di quelli che andranno in pensione”.
Tutto da buttare, quindi? ‘Nì’. Nel senso che per alcune questioni, almeno secondo il sindaco, c’è ancora modo e tempo di recuperare: “Sui medici questa situazione è ormai irrecuperabile (perché se interveniamo oggi, avremo una risposta fra dieci/quindici anni); sulle professioni infermieristiche invece si può ancora correggere la rotta. Questi elementi: finanziamenti, formazione, riconoscimento del ruolo e politiche per aumentare il numero dei professionisti nei prossimi anni saranno temi importanti con un effetto sulla qualità della vita dei cittadini”.
Cosa si sta aspettando, allora? Chissà. Forse, ancora una volta… La narcolettica politica italiana?

Lascia un commento